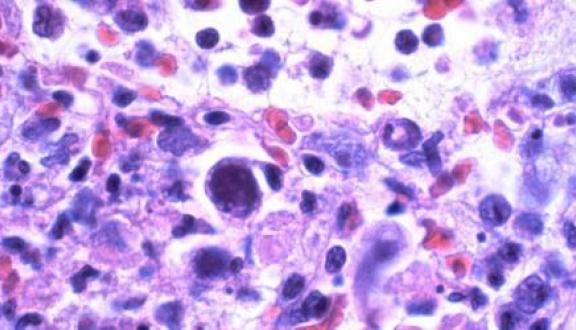

Daniele Lilleri

Daniele Lilleri è ricercatore presso i Laboratori Sperimentali di Ricerca, Fondazione IRCCS Policlinico San Matteo, Pavia, e “visiting scientist” presso l’Istituto di Ricerca in Biomedicina, Bellinzona, Svizzera. È membro della “Società Italiana di Virologia” (SIV), della “European Society for Cinical Virology” (ESCV), della “European Society for Virology” (ESV) e del “Transplantation Society International CMV Consensus Group”.
Daniele Lilleri si è laureato in Medicina e Chirurgia presso l’“Università degli Studi di Pavia” nel 1998 e si è specializzato in Microbiologia e Virologia nel 2003 presso l’“Università degli Studi di Milano”. Ha ricevuto nel 2007 dalla ESCV il premio “Abbott Diagnostic Award” per i suoi contributi originali nel campo della diagnosi virologica. La sua attività di ricerca è stata inizialmente indirizzata verso la messa a punto e la validazione di saggi molecolari per la diagnosi ed il monitoraggio dell’infezione da Citomegalovirus umano (HCMV) nei pazienti immunocompetenti ed immunocompromessi. In seguito si è occupato dello studio della risposta immune anticorpale e cellulo-mediata nei confronti di HCMV. Ha contribuito all’identificazione dei principali caratteri patogenetici dell’infezione da HCMV. Attualmente è il responsabile di un progetto di ricerca, finanziato dal Ministero della Salute dal titolo finalizzato allo studio di un vaccino anti-HCMV.